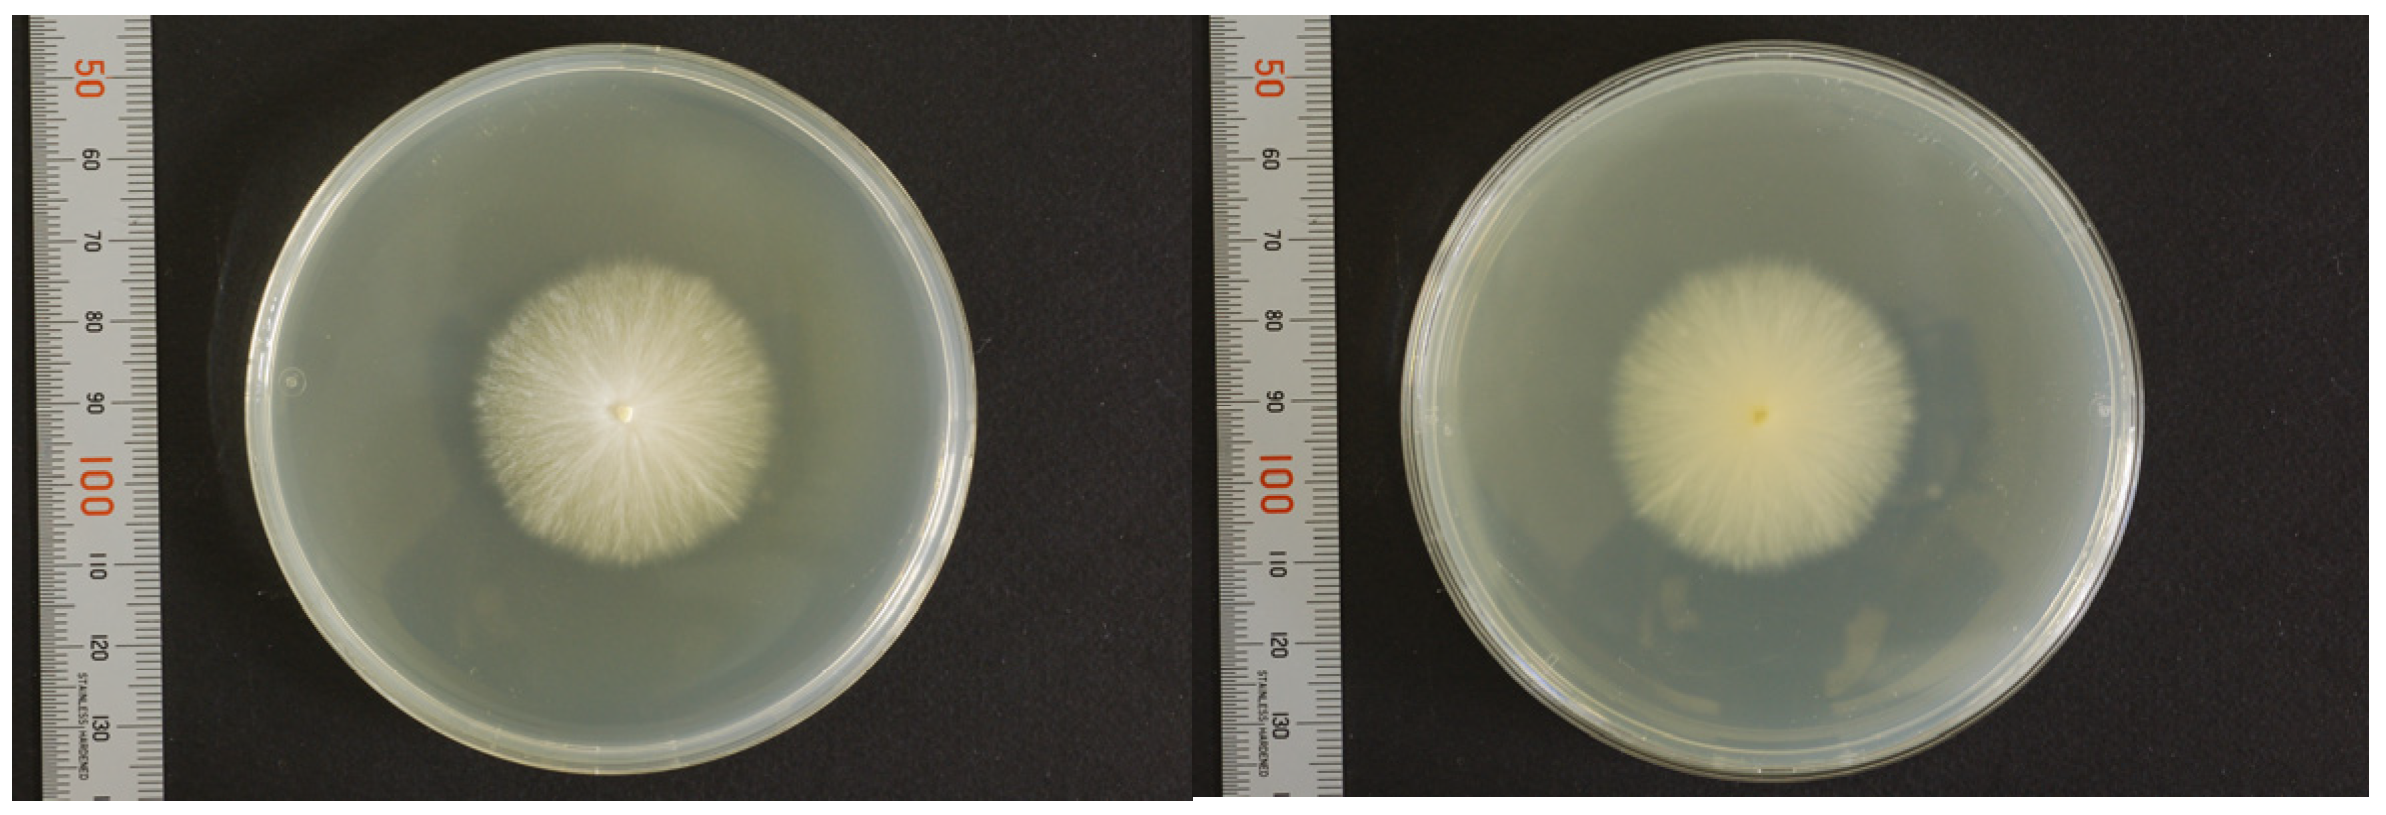
Jof 09 01122 g004 Jof 09 01122 g004
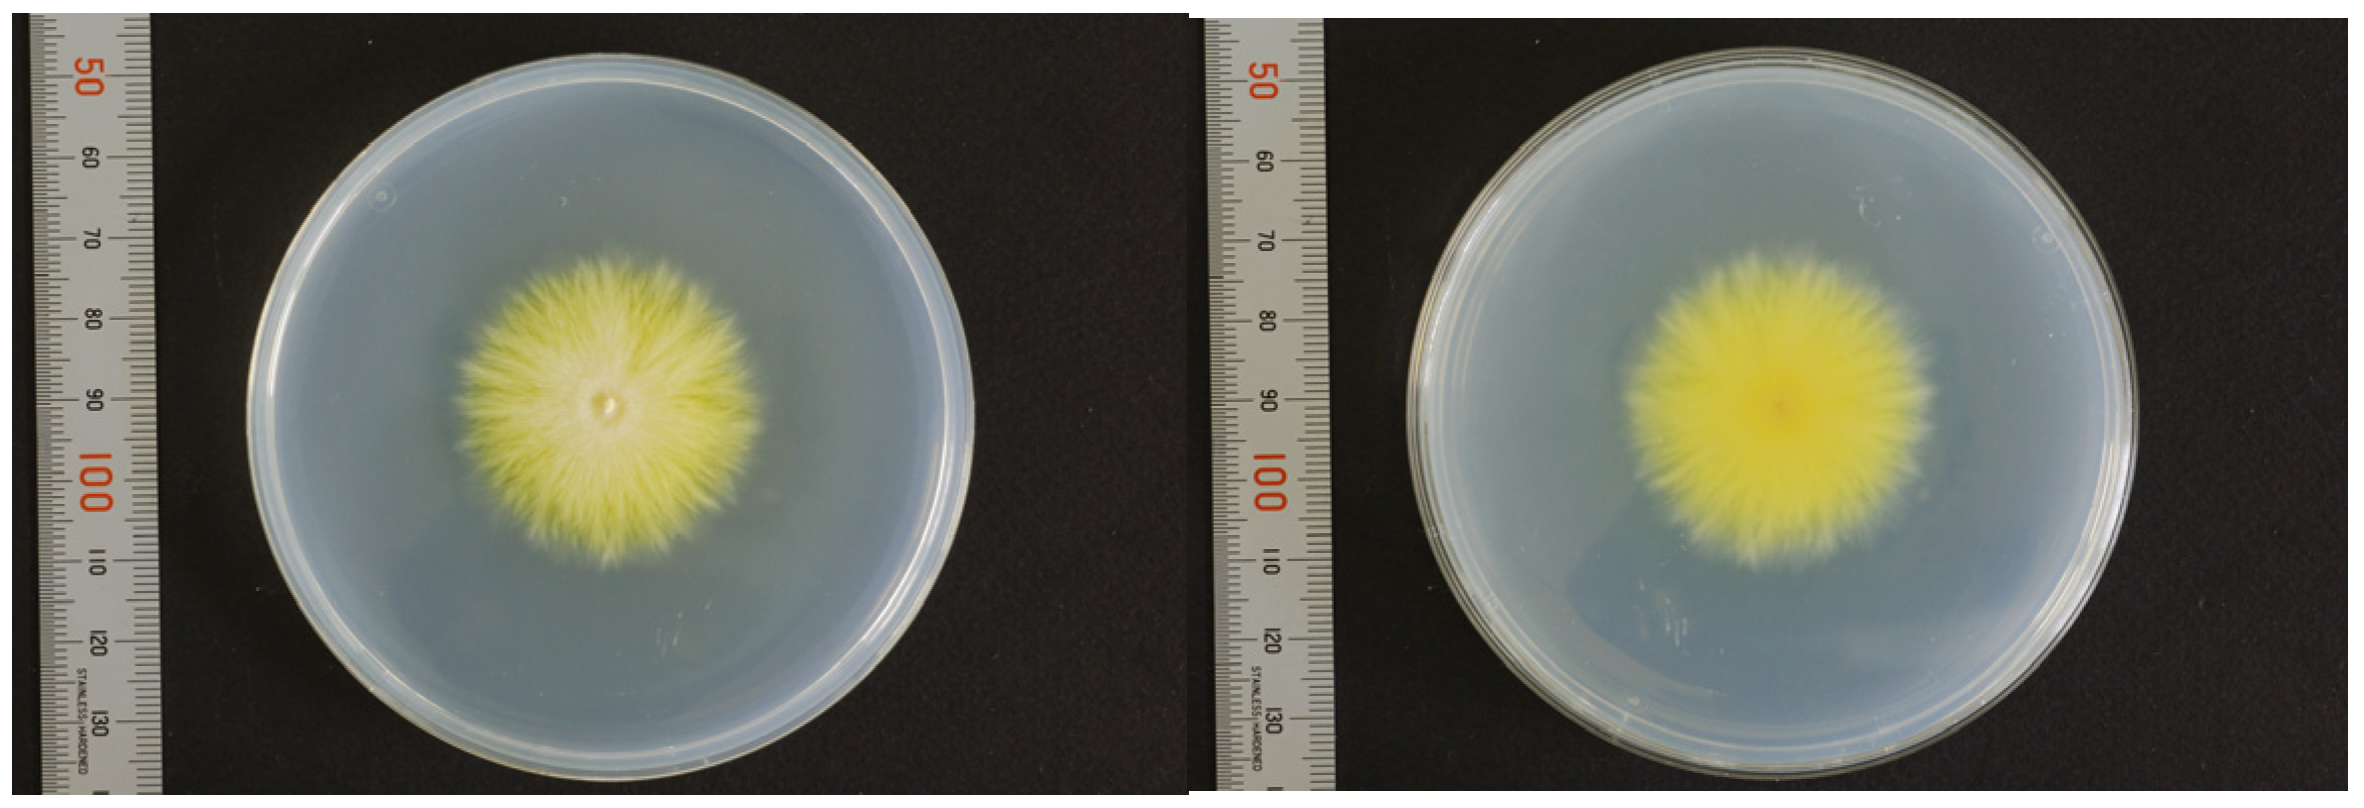
Jof 09 01122 g005 Jof 09 01122 g005

A Case of Tinea Corporis Caused by Trichophyton benhamiae var. luteum from a Degu and Evolution of the Pathogen’s Taxonomy
Abstract
1. Introduction
2. Case Presentation
3. Mycological Findings
3.1. Mating Test
3.2. Molecular Identification
3.3. Mass Spectrometry by MALDI-TOF MS
3.4. Treatment
4. Discussion
4.1. Evolution of the Taxonomy of Trichophyton benhamiae
4.2. Epidemiology and Clinical Impact of T. benhamiae var. luteum Infections in Japan
5. Conclusions
Author Contributions
Funding
Institutional Review Board Statement
Informed Consent Statement
Data Availability Statement
Acknowledgments
Conflicts of Interest
References
- de Hoog, G.S.; Duke, K. Toward a novel multilocus phylogenetic taxonomy for the dermatophytes. Mycopathologia 2017, 182, 5–31. [Google Scholar] [CrossRef] [PubMed]
- Peano, A.; Hubka, V. Cases of dermatophytosis caused by Trichophyton benhamiae var. luteum and T. europaeum, newly described dermatophytes within the T. benhamiae complex. Vet. Dermatol. 2022, 33, 440–445. [Google Scholar] [CrossRef]
- Čmoková, A.; Kolařík, M. Resolving the taxonomy of emerging zoonotic pathogens in the Trichophyton benhamiae complex. Fungal Divers. 2020, 104, 333–387. [Google Scholar] [CrossRef]
- Symoens, F.; Jousson, O. The dermatophyte species Arthroderma benhamiae: Intraspecies variability and mating behavior. J. Med. Microbiol. 2013, 62, 377–385. [Google Scholar] [CrossRef] [PubMed]
- Ajello, L.; Cheng, S.-L. The perfect state of Trichophyton mentagrophytes. Sabouraudia 1967, 5, 230–234. [Google Scholar] [CrossRef] [PubMed]
- Takashio, M. Observations on African and European strains of Arthroderma benhamiae. Int. J. Dermatol. 1974, 13, 94–101. [Google Scholar] [CrossRef] [PubMed]
- Miller, J.S.; Funk, V.A. Outcomes of the 2011 Botanical Nomenclature Section at the XVIII International Botanical Congress. PhytoKeys 2011, 5, 1–3. [Google Scholar] [CrossRef]
- Kano, R.; Sano, A. A new genotype of Arthroderma benhamiae. Med. Mycol. 2008, 46, 739–744. [Google Scholar] [CrossRef]
- Kano, R.; Kawasaki, M. Mating genes of the Trichophyton mentagrophytes complex. Mycopathologia 2012, 173, 103–112. [Google Scholar] [CrossRef]
- Arias, A.F.; Diaz, A. Tinea faciei caused by Trichophyton benhamiae in a child. Pediatr. Dermatol. 2021, 38, 520–521. [Google Scholar] [CrossRef] [PubMed]
- Berlin, M.; Kupsch, C. German-wide analysis of the prevalence and the propagation factors of the zoonotic dermatophyte Trichophyton benhamiae. J. Fungi. 2020, 6, 161. [Google Scholar] [CrossRef]
- Uhrlaß, S.; May-ser, P. Zoophilic dermatophytes during coronavirus pandemic in Germany. Dermatologie 2023, 74, 430–439. (In Germany) [Google Scholar] [CrossRef] [PubMed]
- Hironaga, M.; Watanabe, S. Mating behavior of 334 Japanese isolates of Trichophyton mentagrophytes in relation to their ecological status. Mycologia 1980, 72, 1157–1170. [Google Scholar] [CrossRef]
- Kano, R.; Nakamura, Y. The first isolation of Arthroderma benhamiae in Japan. Microbiol. Immunol. 1999, 42, 575–578. [Google Scholar] [CrossRef] [PubMed]
- Kawasaki, M.; Aso, M. Two cases of tinea corporis by infection from a rabbit with Arthroderma benhamiae. Jpn. J. Med. Mycol. 2000, 41, 263–267. [Google Scholar] [CrossRef] [PubMed]
- Kakutani, H. Two cases of tinea corporis caused by Arthroderma benhamiae from a rabbit. Jpn. J. Clin. Dermatol. 2005, 59, 1334–1337. (In Japanese) [Google Scholar]
- Mochizuki, T. Arthroderma benhamiae infection in Japan. Jpn. J. Clin. Dermatol. 2006, 60, 8–12. (In Japanese) [Google Scholar]
- Fujita, S. Tinea corporis caused by Arthroderma benhamiae from a rabbit. Jpn. J. Clin. Dermatol. 2006, 60, 733–735. (In Japanese) [Google Scholar]
- Nakamura, Y.; Kano, R.A. First report on human ringworm caused by Arthroderma benhamiae in Japan transmitted from a rabbit. Mycoses 2002, 45, 129–131. [Google Scholar] [CrossRef]
- Imafuku, T.; Nishimoto, K. Two cases of dermatophytosis caused by Arthroderma benhamiae. Nishinihon J. Dermatol. 2002, 64, 732–735. (In Japanese) [Google Scholar] [CrossRef]
- Mochizuki, T.; Watanabe, S. A Japanese case of tinea corporis caused by Arthroderma benhamiae. J. Dermatol. 2002, 29, 221–225. [Google Scholar] [CrossRef] [PubMed]
- Yamaguchi, Y. Tinea corporis caused by Trichophyton mentagrophytes from a pet rabbit. Nishinihon J. Dermatol. 2004, 66, 34–36. (In Japanese) [Google Scholar] [CrossRef]
- Tozaki, H.; Hujihiro, M. Tinea manus and tinea corporis caused by Arthroderma benhamiae. Nishinihon J. Dermatol. 2001, 63, 542–545. (In Japanese) [Google Scholar] [CrossRef]
- Hattori, N.; Kaneko, T. A case of kerion celsi due to Arthroderma benhamiae identified by DNA sequences of nuclear ribosomal internal transcribed spacer 1 regions. Med. Mycol. 2003, 41, 249–251. [Google Scholar] [CrossRef] [PubMed][Green Version]
- Sujino, K.; Oouchi, Y. A case of atypical form dermatophytosis caused by Arthroderma benhamiae. Rinsho Derma 2012, 54, 664–665. (In Japanese) [Google Scholar]
- Mochizuki, T.; Kobayashi, H. The first human cases of Americano-European race of Arthroderma benhamiae infection in Japan. Jpn. J. Infect. Dis. 2012, 65, 558–559. [Google Scholar] [CrossRef]
- Yanagihara, M.; Anzawa, K. Tinea corporis caused by Trichophyton benhamiae (Group II). Pract. Dermatol. 2019, 41, 523–526. (In Japanese) [Google Scholar]
- Yamauchi, K.; Miyake, S. Tinea corporis and tinea faciei by Arthroderma benhamiae infected from Guinea pig: A familial cases. Ski. Res. 2018, 17, 196–201. (In Japanese) [Google Scholar]
- Ito, M.; MIzutani, Y. Four Cases of tinea corporis suspected of animal-origin infection. Rinsho Derma 2016, 58, 649–654. (In Japanese) [Google Scholar]
- Kimura, U.; Yokoyama, K. Tinea faciei caused by Trichophyton mentagrophytes (Molecular Type Arthroderma benhamiae) mimics impetigo: A case report and literature review of cases in Japan. Med. Mycol. J. 2015, 56, E1–E5. [Google Scholar] [CrossRef]
- Shiraki, Y.; Hiruma, M. A case of tinea corporis caused by Arthroderma benhamiae (teleomorph of Tinea mentagrophytes) in a pet shop employee. J. Am. Acad. Dermatol. 2006, 55, 153–154. [Google Scholar] [CrossRef]
- Shiraki, Y.; Hiruma, M. Case of tinea capitis caused by Trichophyton mentagrophytes (molecular type Arthroderma benhamiae): Prevalence of a new zoonotic fungal infection in Japan. J. Dermatol. 2006, 33, 504–506. [Google Scholar] [CrossRef] [PubMed]
- Kitami, Y.; Kagawa, S. A case of tinea corporis on the face by Arthroderma benhamiae. Jpn. J. Clin. Dermatol. 2009, 63, 779–782. (In Japanese) [Google Scholar]
- Hiruma, J.; Kano, R. Occurrence of Arthroderma benhamiae genotype in Japan. Mycopathologia 2015, 179, 219–223. [Google Scholar] [CrossRef] [PubMed]
- Saito, K.; Kano, R. Arthroderma benhamiae infection in a rabbit. J. Vet. Med. Sci. 2001, 63, 929–931. [Google Scholar] [CrossRef] [PubMed][Green Version]

Disclaimer/Publisher’s Note: The statements, opinions and data contained in all publications are solely those of the individual author(s) and contributor(s) and not of MDPI and/or the editor(s). MDPI and/or the editor(s) disclaim responsibility for any injury to people or property resulting from any ideas, methods, instructions or products referred to in the content. |
© 2023 by the authors. Licensee MDPI, Basel, Switzerland. This article is an open access article distributed under the terms and conditions of the Creative Commons Attribution (CC BY) license (https://creativecommons.org/licenses/by/4.0/).
Share and Cite
Tanabe, H.; Abe, N.; Anzawa, K. A Case of Tinea Corporis Caused by Trichophyton benhamiae var. luteum from a Degu and Evolution of the Pathogen’s Taxonomy. J. Fungi 2023, 9, 1122. https://doi.org/10.3390/jof9111122
Tanabe H, Abe N, Anzawa K. A Case of Tinea Corporis Caused by Trichophyton benhamiae var. luteum from a Degu and Evolution of the Pathogen’s Taxonomy. Journal of Fungi. 2023; 9(11):1122. https://doi.org/10.3390/jof9111122
Chicago/Turabian StyleTanabe, Hiroshi, Noriyuki Abe, and Kazushi Anzawa. 2023. "A Case of Tinea Corporis Caused by Trichophyton benhamiae var. luteum from a Degu and Evolution of the Pathogen’s Taxonomy" Journal of Fungi 9, no. 11: 1122. https://doi.org/10.3390/jof9111122
APA StyleTanabe, H., Abe, N., & Anzawa, K. (2023). A Case of Tinea Corporis Caused by Trichophyton benhamiae var. luteum from a Degu and Evolution of the Pathogen’s Taxonomy. Journal of Fungi, 9(11), 1122. https://doi.org/10.3390/jof9111122

